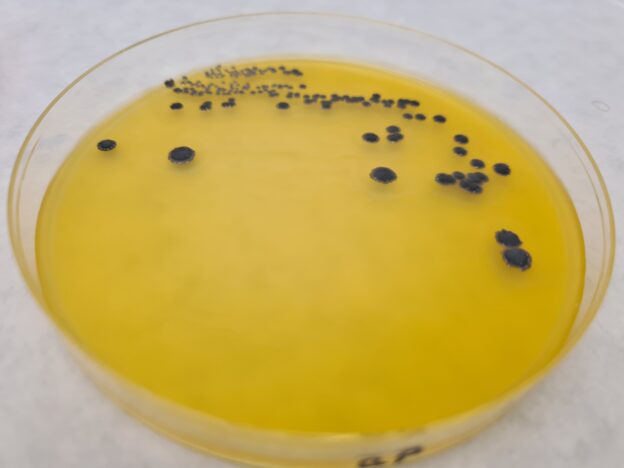

BAIRD PARKER FARMACOPEA AGAR (BASE). PHARMACOPEA MEDIO O, ISO 22718, medio de cultivo para detección de Staphylococcus aureus
Detección y enumeración de Staphylococcus aureus (USP, ISO 22718-cosméticos) 
Colonias típicas de Staphylococcus aureus
COMPOSICIÓN
- Triptona 10.00 g
- Extracto de carne 5.00 g
- Extracto de levadura 1.00 g
- Piruvato sódico 10.00 g
- Glicina 12.00 g
- Cloruro de litio 5.00 g
- Agar-agar 20.00 g
(Fórmula por litro)
pH final: 6,8 ± 0.2
PREPARACIÓN
Disolver 63 g de medio en 1 l de agua bidestilada. Calentar hasta ebullición agitando para su completa disolución. Autoclavar a 121 ºC durante 15 minutos. El color final del medio base es crema y transparente.
PARA USO EXCLUSIVO EN LABORATORIO. AGITE EL BOTE ANTES DE USAR, PARA ASEGURAR LA HOMOGENEIZACIÓN DE LOS EVENTUALES GRADIENTES DE DENSIDAD DE LOS COMPONENTES. MUY HIGROSCÓPICO: MANTENGA EL BOTE BIEN CERRADO EN LUGAR SECO, FRESCO Y OSCURO.
DESHIDRATADO CODIGO: DMT306
CONTROL DE CALIDAD DEL MEDIO
Realizado en nuestro laboratorio; es prudente repetirlo en su laboratorio siempre que varíen las condiciones (más de 3 meses sin usar, tras desinfectar laboratorio, tras conservar a alta Tª, cuando adquiere aspectos extraños aunque no haya llegado la fecha de caducidad teórica de la etiqueta,…)
DESHIDRATADO: Polvo, tostado
PREPARADO: Estéril, Crema, Opaco
CONTROL DE CRECIMIENTO CUANTITATIVO 48 h a aprox.37°C:
- Bacillus subtilis MKTA 6633, Escaso, Colonia marrón.
- Proteus mirabilis MKTA 14153, Excelente, Colonia marrón.
- Staphylococcus aureus MKTA 6538P, Excelente, Colonia negra, Con reborde blanco y amplio halo. Con respecto a PCA estandarizado*, recuento 73-95 %, pero de forma selectiva.
- Staphylococcus epidermidis MKTA 12228, Bueno, Colonia negra, sin halo.
* El que cumple con recuperación superior al 92-125% con respecto a cepas cuantitativas trazables a cepa tipo. Incertidumbres detectadas entre todos los lotes a lo largo de un año (la mayoría de la incertidumbre se debe a la cepa y a la proporción de cepas acompañantes inoculadas, no al medio)
PRESENTACIÓN: MEDIO DESHIDRATADO BASE + SUPLEMENTO.
NOTA: Medio selectivo y diferencial para la detección y enumeración de S. aureus en alimentos y productos farmacéuticos. El Cloruro de Litio, el Telurito Potásico y la Glicina inhiben la flora acompañante. La yema de huevo demuestra la actividad lecitinasa. Si la muestra es rica en mohos, se pueden eliminar añadiendo al medio enfriado a 45°C, 0,05-0,5 g/l de Cicloheximida (SKM200).
SIEMBRA
Dejar enfriar el medio BASE a 48 ºC y mezclar bien con 50 ml/l de emulsión estéril de yema de huevo con telurito potásico (SBH011). El color final del medio completo es crema y algo opaco. Añadir 20 ml/placa. Sembrar la placa con 0,1 ml de la muestra y sus diluciones, en superficie, con un triángulo de vidrio estéril VRR154 o con asas de Digralsky desechables (VCL155). O bien por agotamiento si la muestra procede de enriquecimiento y por consiguiente, no es para realizar recuentos. Incubar 48 horas a 35-38 ºC.
INTERPRETACIÓN
S.aureus forma colonias características (negras o grises, brillantes, convexas, de 1,5-2,5 mm, a menudo con reborde opalescente-blanco, rodeadas de un halo claro de 2‑5 mm de diámetro (lísis de la yema de huevo). Sospechar también de las colonias atípicas (negras brillantes y grises, sin halo). Confirmar la coagulasa con el látex inmediato KWD094 o bien con incubación en BHI (DMT022, RPL004, TPL003), 22-26 h a 35-37 °C si, tras 4-6 h de añadir 0,3 ml de plasma de conejo, a 35-37°C, el coágulo supera la mitad del volumen original. Otros estafilococos, Micrococcus y Bacillus forman colonias sin alguna de las características descritas. Para descartar los falsos positivos de Micrococos, realizar una citocromo-oxidasa (con las tiras estables KOT050), ya que los Staphylococcus spp. son oxidasa negativos pero los Micrococcus spp. son oxidasa positivos.
Si desea más información sobre nuestros Medio BAIRD PARKER AGAR rellene nuestro formulario de contacto http://www.medioscultivo.com/contacto . O si lo prefiere póngase en contacto con nosotros a través de nuestro correo electrónico microkit@microkit.es o por teléfono en el nº 91-897 46 16
https://www.microkit.es/fichas/BAIRD-PARKER-AGAR-Pharmacopea.pdf